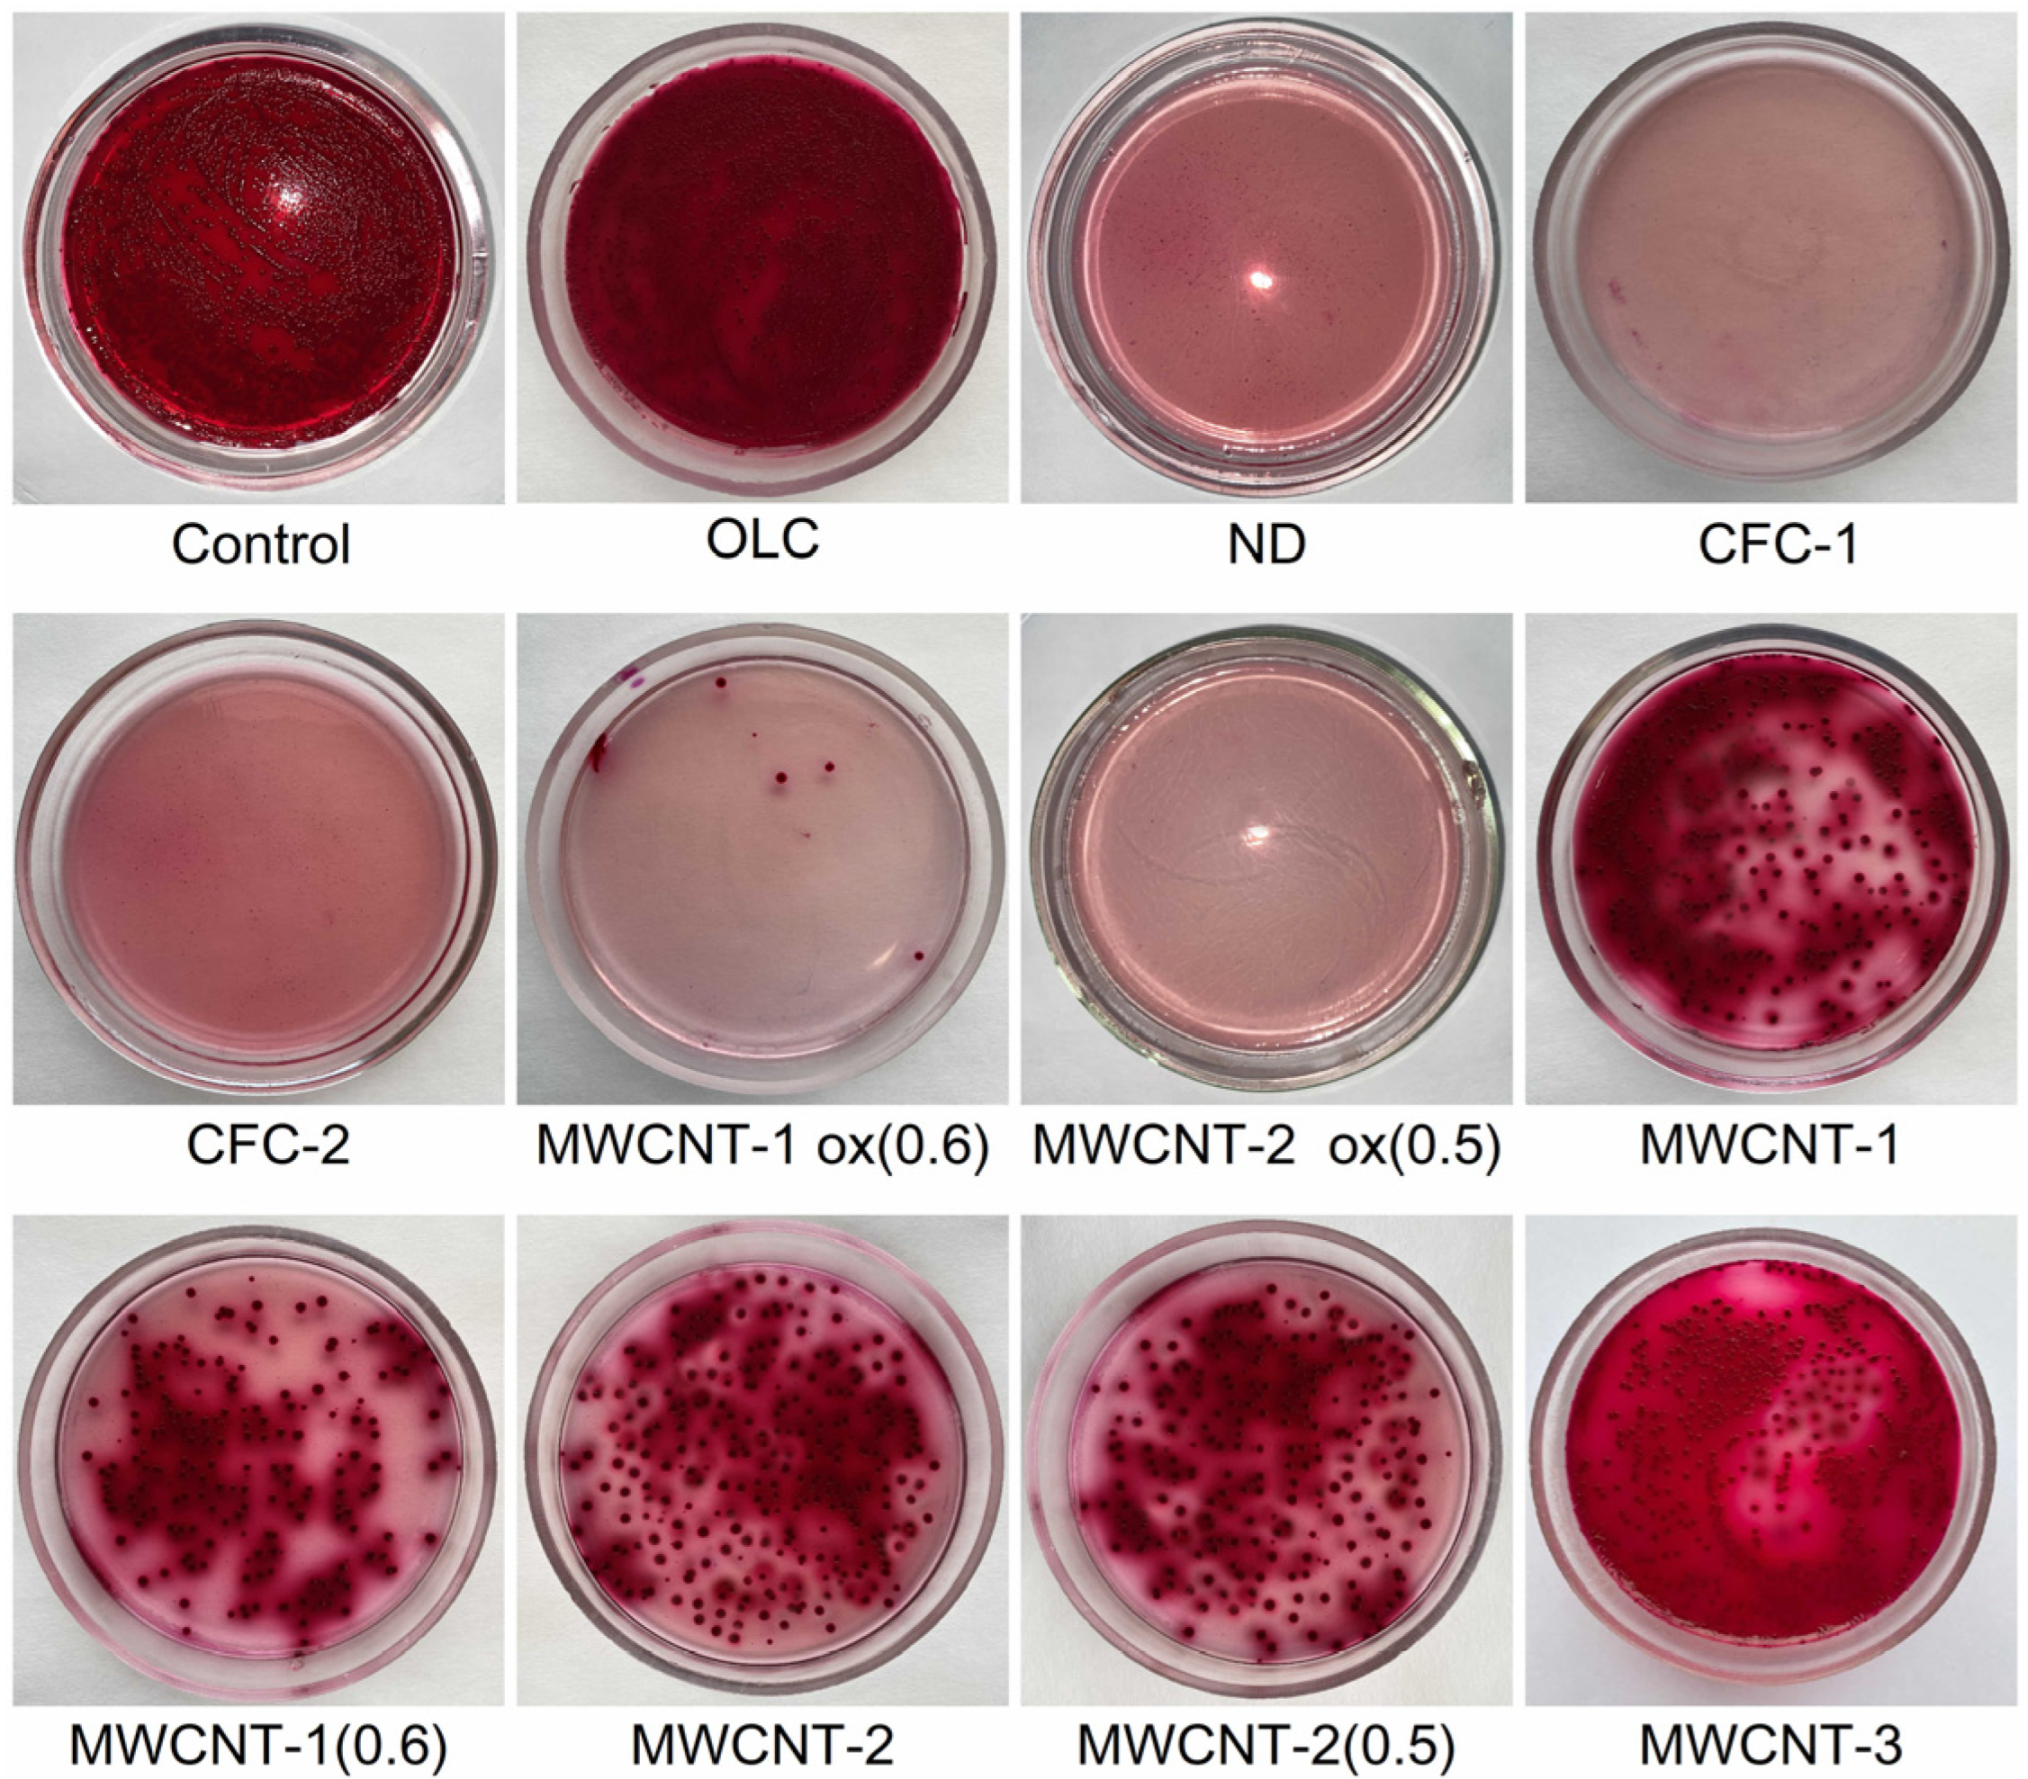
Materials 16 00957 g002

Antibacterial Effect of Carbon Nanomaterials: Nanotubes, Carbon Nanofibers, Nanodiamonds, and Onion-like Carbon
Abstract
1. Introduction
2. Materials and Methods
2.1. Nanomaterials
- (1)
- Nanodiamonds (ND, sp3-hybridized carbon material, primary particle mean size 5 nm, Figure S1) were produced by FGUP “Altay” (Biysk, Russia) using detonation of a trotyl/cyclotrimethylene–trinitroamine mixture (TNT/RDX = 50:50) according to the procedure described elsewhere [26] and purified with a mixture of nitric and sulfuric acids [27].
- (2)
- (3)
- Catalytic filamentous carbon (CFC-I, Figure S3A) was produced through methane decomposition over a 90Ni–Al2O3 catalyst. In CFC-1, the graphite-like planes are oriented coaxially, with the angle between the planes and the filament axis varying from 45 to 75° [30,31].
- (4)
- CFC-2 (Figure S3B) was produced via methane decomposition over a 75Ni–15Cu–Al2O3 catalyst. CFC-2 consists of graphite-like planes stacked perpendicular to the filament axis [31].
- (5)
- A set of multiwalled carbon nanotubes (MWCNTs, Figure S4) with variable external diameters and lengths (Table 1) was produced using the CCVD technique in the reaction mixture of C2H4 and Ar (50:50) at 650–670 °C with Fe–Co catalysts [32,33,34,35,36]. Primary MWCNTs exist in the form of agglomerates consisting of randomly entangled nanotubes [35]. To remove catalyst residues, the MWCNT samples were boiled in diluted HCl (1:1) for 2 h, which was followed by washing with distilled water to neutral reaction and air-drying at 80 °C for 2 days. To obtain short MWCNTs, milling in an APF-type plantar mill was used. Further in the text, the following constructions are used to designate short nanotubes: in the notation MWNT-A (L), A (values 1,2,3) refer to nanotubes with an average diameter of 7.8, 10, and 18 nm, respectively; the numbers in brackets (L) correspond to the average length of nanotubes in µm. Thus, MWCNT-2 (0.6) corresponds to nanotubes with an average diameter of 10 nm and a length near 0.6 μm.
2.2. Microorganisms
2.3. Media and Cultivation Conditions
2.4. A Study of the Antimicrobial Efficacy of Nanoparticles In Vitro
2.5. Microscopic Methods
3. Results and Discussion
3.1. Determination of the Antimicrobial Efficacy of CNMs
3.1.1. CFCs
3.1.2. MWCNTs
3.1.3. Nanodiamonds
3.1.4. OLC
3.2. Influence of the Content of Oxygen-Containing Groups on the Antibacterial Effects of CNMs
3.3. Influence of the Liquid Medium on the Antimicrobial Effects of CNM
4. Conclusions
Supplementary Materials
Author Contributions
Funding
Institutional Review Board Statement
Informed Consent Statement
Data Availability Statement
Acknowledgments
Conflicts of Interest
References
- Joakim Larsson, D.G.; Flach, C.-F. Antibiotic resistance in the environment. Nat. Rev. Microbiol. 2022, 20, 257–269. [Google Scholar] [CrossRef] [PubMed]
- Reygaert, W.C. An overview of the antimicrobial resistance mechanisms of bacteria. AIMS Microbiol. 2018, 4, 482–501. [Google Scholar] [CrossRef]
- Munita, J.M.; Arias, C.A. Mechanisms of Antibiotic Resistance. Microbiol. Spectr. 2016, 4, 464–473. [Google Scholar] [CrossRef] [PubMed]
- Peterson, E.; Kaur, P. Antibiotic Resistance Mechanisms in Bacteria: Relationships Between Resistance Determinants of Antibiotic Producers, Environmental Bacteria, and Clinical Pathogens. Front. Microbiol. 2018, 9, 2928. [Google Scholar] [CrossRef] [PubMed]
- Abushaheen, M.A.; Muzaheed; Fatani, A.J.; Alosaimi, M.; Mansy, W.; George, M.; Acharya, S.; Rathod, S.; Divakar, D.D.; Jhugroo, C.; et al. Antimicrobial resistance, mechanisms and its clinical significance. Disease-a-Month 2020, 66, 100971. [Google Scholar] [CrossRef] [PubMed]
- Global Priority List of Antibiotic Resistant Bacteria to Guide Research. In Discovery, and Development of New Antibiotics; WHO: Geneva, Switzerland, 2017.
- Antimicrobial Resistance; WHO: Geneva, Switzerland, 2021; Available online: https://www.who.int/news-room/fact-sheets/detail/antimicrobial-resistance (accessed on 30 October 2022).
- Hassani, M.; Tahghighi, A.; Rohani, M.; Hekmati, M.; Ahmadian, M.; Ahmadvand, H. Robust antibacterial activity of functionalized carbon nanotube-levofloxacine conjugate based on in vitro and in vivo studies. Sci. Rep. 2022, 12, 10064. [Google Scholar] [CrossRef] [PubMed]
- Shen, T.; Chernysheva, M.G.; Badun, G.A.; Popov, A.G.; Egorov, A.V.; Anuchina, N.M.; Chaschin, I.S.; Bakuleva, N.P. Levofloxacin and Amikacin Adsorption on Nanodiamonds: Mechanism and Application Prospects. Colloids Interfaces 2022, 6, 35. [Google Scholar] [CrossRef]
- Teradal, N.L.; Jelinek, R. Carbon Nanomaterials in Biological Studies and Biomedicine. Adv. Healthc. Mater. 2017, 6, 1700574. [Google Scholar] [CrossRef]
- Hartono, M.R.; Kushmaro, A.; Chen, X.; Marks, R.S. Probing the toxicity mechanism of multiwalled carbon nanotubes on bacteria. Environ. Sci. Pollut. Res. Int. 2018, 25, 5003–5012. [Google Scholar] [CrossRef]
- Ramos, A.P.; Cruz, M.A.E.; Tovani, C.B.; Ciancaglini, P. Biomedical applications of nanotechnology. Biophys. Rev. 2017, 9, 79–89. [Google Scholar] [CrossRef]
- Chetyrkina, M.R.; Fedorov, F.S.; Nasibulin, A.G. In vitro toxicity of carbon nanotubes: A systematic review. RSC Adv. 2022, 12, 16235–16256. [Google Scholar] [CrossRef] [PubMed]
- Saleemi, M.A.; Fouladi, M.H.; Yong, P.V.C.; Wong, E.H. Elucidation of Antimicrobial Activity of Non-Covalently Dispersed Carbon Nanotubes. Materials 2020, 13, 1676. [Google Scholar] [CrossRef] [PubMed]
- Dizaj, S.M.; Mennati, A.; Jafari, S.; Khezri, K.; Adibkia, K. Antimicrobial Activity of Carbon-Based Nanoparticles. Adv. Pharm. Bull. 2015, 5, 19–23. [Google Scholar] [CrossRef]
- Seo, Y.; Park, C.; Son, J.; Lee, K.; Hwan, J.; Jo, Y.; Lee, D.; Khan, M.S. Synthesis of Multi-walled Carbon Nanotubes Modified with Silver Nanoparticles and Evaluation of Their Antibacterial Activities and Cytotoxic Properties. J. Vis. Exp. 2018, 135, 57384. [Google Scholar] [CrossRef] [PubMed]
- Baek, S.; Joo, S.H.; Su, C.; Toborek, M. Antibacterial effects of graphene- and carbon-nanotube-based nanohybrids on Escherichia coli: Implications for treating multidrug-resistant bacteria. J. Environ. Manag. 2019, 247, 214–223. [Google Scholar] [CrossRef]
- Kumar, P.; Huo, P.; Zhang, R.; Liu, B. Antibacterial Properties of Graphene-Based Nanomaterials. Nanomaterials 2019, 9, 737. [Google Scholar] [CrossRef] [PubMed]
- Mocan, T.; Matea, C.T.; Pop, T.; Mosteanu, O.; Buzoianu, A.D.; Suciu, S.; Puia, C.; Zdrehus, C.; Iancu, C.; Mocan, L. Carbon nanotubes as anti-bacterial agents. Cell. Mol. Life Sci. 2017, 74, 3467–3479. [Google Scholar] [CrossRef] [PubMed]
- Maas, M. Carbon Nanomaterials as Antibacterial Colloids. Materials. 2016, 9, 617. [Google Scholar] [CrossRef] [PubMed]
- Kovach, K.; Kirisits, M.J.; Gordon, V.D. Suspended multiwalled, acid-functionalized carbon nanotubes promote aggregation of the opportunistic pathogen Pseudomonas aeruginosa. PLoS ONE 2020, 15, e0236599. [Google Scholar] [CrossRef] [PubMed]
- Kang, S.; Herzberg, M.; Rodrigues, D.F.; Elimelech, M. Antibacterial Effects of Carbon Nanotubes: Size Does Matter! Langmuir 2008, 24, 6409–6413. [Google Scholar] [CrossRef]
- Al-Jumaili, A.; Alancherry, S.; Bazaka, K.; Jacob, M.V. Review on the Antimicrobial Properties of Carbon Nanostructures. Materials 2017, 10, 1066. [Google Scholar] [CrossRef] [PubMed]
- Wang, L.; Hu, C.; Shao, L. The antimicrobial activity of nanoparticles: Present situation and prospects for the future. Int. J. Nanomed. 2017, 12, 1227–1249. [Google Scholar] [CrossRef] [PubMed]
- Kandi, V.; Kandi, S. Antimicrobial properties of nanomolecules: Potential candidates as antibiotics in the era of multi-drug resistance. Epidemiol. Health 2015, 37, e2015020. [Google Scholar] [CrossRef] [PubMed]
- Kuznetsov, V.L.; Aleksandrov, M.N.; Zagoruiko, I.V.; Chuvilin, A.L.; Moroz, E.M.; Kolomiichuk, V.N.; Likholobov, V.A.; Brylyakov, P.M.; Sakovitch, G.V. Study of Ultradispersed Diamond Powders Obtained Using Explosion Energy. Carbon 1991, 29, 665–668. [Google Scholar] [CrossRef]
- Gubarevich, T.; Larionova, I.S.; Ryzhko, G.A.; Kostyukova, N.M.; Sataev, R.R. USSR Patent 1,830,883, 13 October 1992.
- Kuznetsov, V.L.; Chuvilin, A.L.; Butenko, Y.V.; Mal’kov, I.Y.; Titov, V.M. Onion-like Carbon from Ultra-Disperse Diamond. Chem. Phys. Lett. 1994, 222, 343–348. [Google Scholar] [CrossRef]
- Kuznetsov, V.L.; Butenko, Y.V. Diamond Phase Transitions at Nanoscale. In Ultrananocrystalline Diamond: Synthesis, Properties and Applications, Second Edition; Shenderova, O., Gruen, D., Eds.; Elsevier: Amsterdam, The Netherlands, 2012; pp. 181–244. ISBN 1437734650. [Google Scholar] [CrossRef]
- Shaikhutdinov, S.K.; Avdeeva, L.B.; Goncharova, O.V.; Kochubey, D.I.; Novgorodov, B.N.; Plyasova, L.M. Coprecipitated Ni-Al and Ni-Cu-Al Catalysts for Methane Decomposition and Carbon Deposition I. Genesis of Calcined and Reduced Catalysts. Appl. Catal. A Gen. 1995, 126, 125–139. [Google Scholar] [CrossRef]
- Reshetenko, T.V.; Avdeeva, L.B.; Ismagilov, Z.R.; Chuvilin, A.L.; Ushakov, V.A. Carbon Capacious Ni-Cu-Al2O3 Catalysts for High-Temperature Methane Decomposition. Appl. Catal. A Gen. 2003, 247, 51–63. [Google Scholar] [CrossRef]
- Kuznetsov, V.L.; Krasnikov, D.V.; Schmakov, A.N.; Elumeeva, K.V. In situ and ex situ Time Resolved Study of Multi-Component Fe-Co Oxide Catalyst Activation During MWNT Synthesis. Phys. Status Solidi B Basic Res. 2012, 249, 2390–2394. [Google Scholar] [CrossRef]
- Kuznetsov, V.L.; Bokova-Sirosh, S.N.; Moseenkov, S.I.; Ishchenko, A.V.; Krasnikov, D.V.; Kazakova, M.A.; Romanenko, A.I.; Tkachev, E.N.; Obraztsova, E.D. Raman Spectra for Characterization of Defective CVD Multi-Walled Carbon Nanotubes. Phys. Status Solidi B Basic Res. 2014, 251, 2444–2450. [Google Scholar] [CrossRef]
- Usoltseva, A.; Kuznetsov, V.; Rudina, N.; Moroz, E.; Haluska, M.; Roth, S. Influence of Catalysts’ Activation on Their Activity and Selectivity in Carbon Nanotubes Synthesis. Phys. Status Solidi B Basic Res. 2007, 244, 3920–3924. [Google Scholar] [CrossRef]
- Kuznetsov, V.L.; Moseenkov, S.I.; Zavorin, A.V.; Golubtsov, G.V.; Goidin, V.V.; Rabinovich, O.S.; Malinouski, A.I.; Lyah, M.Y. Influence of Catalyst Characteristics on the Formation of MWCNT Agglomerates During the Synthesis in a Fluidized Bed Reactor. Chem. Eng. J. 2022, 447, 137391. [Google Scholar] [CrossRef]
- Available online: https://en.catalysis.ru/block/index.php?ID=27&SECTION_ID=1686 (accessed on 15 January 2010).
- Mazov, I.; Kuznetsov, V.L.; Simonova, I.A.; Stadnichenko, A.I.; Ishchenko, A.V.; Romanenko, A.I.; Tkachev, E.N.; Anikeeva, O.B. Oxidation Behavior of Multiwall Carbon Nanotubes with Different Diameters and Morphology. Appl. Surf. Sci. 2012, 258, 6272–6280. [Google Scholar] [CrossRef]
- Boehm, H.P. Chemical identification of surface groups. Adv. Catal. 1966, 16, 179–274. [Google Scholar] [CrossRef]
- Kazakova, M.A.; Moseenkov, S.I.; Golubtsov, G.V.; Korovin, E.Y.; Ishchenko, A.V.; Selyutin, A.G.; Zavorin, A.V.; Zhuravlev, V.A.; Suslyaev, V.I.; Kuznetsov, V.L. Structural and Electromagnetic Properties of Fe2Co-multi-walled Carbon Nanotubes-Polystyrene Based Composite. J. Alloys Compd. 2020, 844, 156107. [Google Scholar] [CrossRef]
- Norouzi, N.; Ong, Y.; Damle, V.G.; Najafi, M.B.H.; Schirhagl, R. Effect of medium and aggregation on antibacterial activity of nanodiamonds. Mater. Sci. Eng. c-Biomim. Supramol. Syst. 2020, 112, 110930. [Google Scholar] [CrossRef]
- Jiang, T.; Amadei, C.A.; Gou, N.; Lin, Y.; Lan, J.; Vecitis, C.D.; Gu, A.Z. Toxicity of Single-Walled Carbon Nanotubes (SWCNTs): Effect of Lengths, Functional Groups and Electronic Structures Revealed by a Quantitative Toxicogenomics Assay. Environ. Sci. Nano. 2020, 7, 1348–1364. [Google Scholar] [CrossRef]
- Teixeira-Santos, R.; Gomes, M.; Gomes, L.C.; Mergulhão, F.J. Antimicrobial and anti-adhesive properties of carbon nanotube-based surfaces for medical applications: A systematic review. Science 2020, 24, 102001. [Google Scholar] [CrossRef]
- Olivi, M.; Zanni, E.; de Bellis, G.; Talora, C.; Sarto, M.S.; Pallesch, C.; Flahaut, E.; Monthioux, M.; Rapino, S.; Uccelletti, D.; et al. Inhibition of microbial growth by carbon nanotube networks. Nanoscale 2013, 5, 9023–9029. [Google Scholar] [CrossRef]
- Maksimova, Y.G. Microorganisms and carbon nanotubes: Interaction and applications. Appl. Biochem. Microbiol. 2019, 55, 1. [Google Scholar] [CrossRef]
- Rajabathar, J.R.; Periyasami, G.; Alanazi, A.M.; Govindasamy, M.; Arunachalam, P. Review on Carbon Nanotube Varieties for Healthcare Application: Effect of Preparation Methods and Mechanism Insight. Processes 2020, 8, 1654. [Google Scholar] [CrossRef]
- Chen, M.; Sun, Y.; Liang, J.; Zeng, G.; Li, Z.; Tang, L.; Zhu, Y.; Jiang, D.; Song, B. Understanding the influence of carbon nanomaterials on microbial communities. Environ. Int. 2019, 126, 690–698. [Google Scholar] [CrossRef] [PubMed]
- Xin, Q.; Shah, H.; Nawaz, A.; Xie, W.; Akram, M.Z.; Batool, A.; Tian, L.; Jan, S.U.; Boddula, R.; Guo, B.; et al. Antibacterial Carbon-Based Nanomaterials. Adv. Mater. 2019, 31, e1804838. [Google Scholar] [CrossRef] [PubMed]
- Szunerits, S.; Barras, S.; Boukherroub, R. Antibacterial Applications of Nanodiamonds. Int. J. Environ. Res. Public Health 2016, 13, 413. [Google Scholar] [CrossRef] [PubMed]
- Cumont, A.; Pitt, A.R.; Lambert, P.A.; Oggioni, M.R.; Ye, H. Properties, mechanism and applications of diamond as an antibacterial material. Funct. Diam. 2020, 1, 1–28. [Google Scholar] [CrossRef]
- Schrand, A.M.; Huang, H.; Carlson, C.; Schlager, J.J.; Osawa, E.; Hussain, S.M.; Dai, L. Are diamond nanoparticles cytotoxic? J. Phys. Chem. B 2007, 111, 2–7. [Google Scholar] [CrossRef]
- Wehling, J.; Dringen, R.; Zare, R.N.; Maas, M.; Rezwan, K. Bactericidal activity of partially oxidized nanodiamonds. ACS Nano 2014, 8, 6475–6483. [Google Scholar] [CrossRef]
- Marchesano, V.; Ambrosone, A.; Bartelmess, J.; Strisciante, F.; Tino, A.; Echegoyen, L.; Tortiglione, C.; Giordani, S. Impact of Carbon Nano-Onions on Hydra vulgaris as a Model Organism for Nanoecotoxicology. Nanomaterials 2015, 5, 1331–1350. [Google Scholar] [CrossRef]
- Jang, J.; Kim, Y.; Hwang, J.; Choi, Y.; Tanaka, M.; Kang, E.; Choi, J. Biological Responses of Onion-Shaped Carbon Nanoparticles. Nanomaterials 2019, 9, 1016. [Google Scholar] [CrossRef]
- Ayşe, E.; Eliuz, E. Antimicrobial activity of citric acid against Escherichia coli, Staphylococcus aureus and Candida albicans as a sanitizer agent. Eurasian J. For. Sci. 2020, 8, 295–301. [Google Scholar] [CrossRef]
- Asati, S.; Sahu, A.; Jain, A. Nanotoxicity: The Dark Side of Nanoformulations. Curr. Nanotoxicity Prev. 2021, 1, 6–25. [Google Scholar] [CrossRef]
- Kobayashi, N.; Izumi, H.; Morimoto, Y. Review of toxicity studies of carbon nanotubes. J. Occup. Health 2017, 59, 394–407. [Google Scholar] [CrossRef] [PubMed]
- Yuan, X.; Zhang, X.; Sun, L.; Wei, Y.; Wei, X. Cellular Toxicity and Immunological Effects of Carbon-based Nanomaterials. Part. Fibre Toxicol. 2019, 16, 18. [Google Scholar] [CrossRef] [PubMed]
- Madannejad, R.; Shoaie, N.; Jahanpeyma, F.; Darvishi, M.H.; Azimzadeh, M.; Javadi, H. Toxicity of carbon-based nanomaterials: Reviewing recent reports in medical and biological systems. Chem. Biol. Interact. 2019, 307, 206–222. [Google Scholar] [CrossRef] [PubMed]

| Nanocarbons * | ||||||
|---|---|---|---|---|---|---|
| Nano- Diamonds (ND) | Onion-like Carbon (OLC) | Carbon Nanofibers (CFC-1), | Carbon Nanofibers (CFC-2) | MWCNTs | MWCNT-ox | |
| Structure | ![]() | ![]() | ![]() | ![]() | ![]() | ![]() |
| SBET (m2/g) | 350–370 | 500 | 90–110 | 140–160 | MWCNT-1 360 (d = 7.8 nm, L = 40 µm) MWCNT-2 260 (d = 10 nm, L = 30 µm) MWCNT-3 120 (d = 18 nm, L = 20 µm) | MWCNT-1ox (0.6) 340–350 MWCNT-2ox (0.5) 250–280 |
| V pore, m3/g | 0.79 | 1.09 | 0.29 | 0.43 | 1.5–1.65 | 1.5–1.8 |
| Number of –COOH/nm21 | 3.1 | <0.1 | 11.9 | 7.8 | 0.2–0.8 | 2.1–2.4 |
| Carbon content, % | >99.9 | >99.9 | >99.5 | >99.5 | >99.5 | >99.5 |
| CNM | Content of COOH/1 nm2 | CFU % after 24 h Exposure of E. coli and CNMs | CFU % after 24 h Exposure of E. coli and CNMs Treated at 800 °C in H2 |
|---|---|---|---|
| CFC-2 | 7.78 | 0 | 0 |
| MWCNT-2ox (0.5) | 2.13 | 0 | 0 |
| NDs | 3.13 | 0 | 0 |
Disclaimer/Publisher’s Note: The statements, opinions and data contained in all publications are solely those of the individual author(s) and contributor(s) and not of MDPI and/or the editor(s). MDPI and/or the editor(s) disclaim responsibility for any injury to people or property resulting from any ideas, methods, instructions or products referred to in the content. |
© 2023 by the authors. Licensee MDPI, Basel, Switzerland. This article is an open access article distributed under the terms and conditions of the Creative Commons Attribution (CC BY) license (https://creativecommons.org/licenses/by/4.0/).
Share and Cite
Moskvitina, E.; Kuznetsov, V.; Moseenkov, S.; Serkova, A.; Zavorin, A. Antibacterial Effect of Carbon Nanomaterials: Nanotubes, Carbon Nanofibers, Nanodiamonds, and Onion-like Carbon. Materials 2023, 16, 957. https://doi.org/10.3390/ma16030957
Moskvitina E, Kuznetsov V, Moseenkov S, Serkova A, Zavorin A. Antibacterial Effect of Carbon Nanomaterials: Nanotubes, Carbon Nanofibers, Nanodiamonds, and Onion-like Carbon. Materials. 2023; 16(3):957. https://doi.org/10.3390/ma16030957
Chicago/Turabian StyleMoskvitina, Ekaterina, Vladimir Kuznetsov, Sergey Moseenkov, Aleksandra Serkova, and Alexey Zavorin. 2023. "Antibacterial Effect of Carbon Nanomaterials: Nanotubes, Carbon Nanofibers, Nanodiamonds, and Onion-like Carbon" Materials 16, no. 3: 957. https://doi.org/10.3390/ma16030957
APA StyleMoskvitina, E., Kuznetsov, V., Moseenkov, S., Serkova, A., & Zavorin, A. (2023). Antibacterial Effect of Carbon Nanomaterials: Nanotubes, Carbon Nanofibers, Nanodiamonds, and Onion-like Carbon. Materials, 16(3), 957. https://doi.org/10.3390/ma16030957







